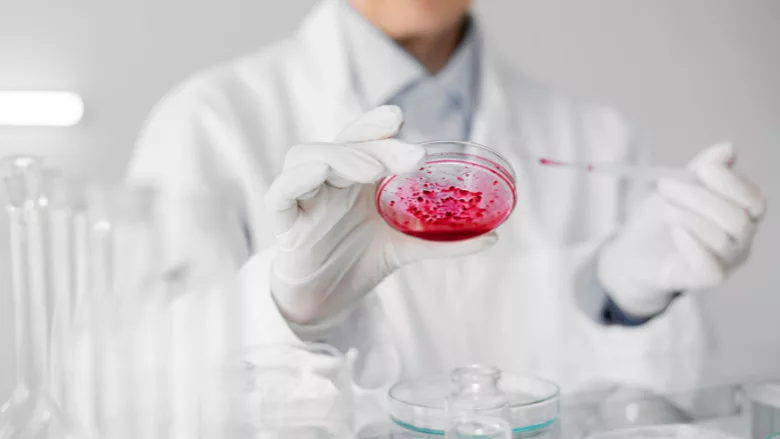

USDA-FSIS Publishes Science Behind New Campylobacter Enrichment Method
Image credit: Freepik
In October 2024, the U.S. Department of Agriculture’s Food Safety and Inspection Service (USDA-FSIS) updated the Microbiology Laboratory Guidebook (MLG) to reflect a new Campylobacter enrichment method used by FSIS field service laboratories. In July 2025, FSIS published the scientific article supporting the use of this new enrichment method in the peer-reviewed journal Food Protection Trends.
The article identifies and evaluates Campylobacter enrichment broths capable of 24-hour enrichment. In 2021, FSIS tested four enrichment broths in five poultry products for maximal recovery of Campylobacter. The enrichment broths were then evaluated for the minimum time-to-results with the goal of identifying a method that might best optimize reporting time. The data collected during this study informed updates to the MLG (MLG 41), which contains test methods used by the FSIS Field Service Laboratories to support FSIS regulatory sampling and testing activities.
In March 2022, FSIS began using a new Campylobacter enrichment medium at all three field service laboratories to analyze poultry samples. This update reduced the enrichment incubation time from approximately 48 to 24 hours. It also resulted in reduced reporting times from three to two days for a screened negative result, and from five to four days for a confirmed positive result.
Open access will be available for the article in December 2025. In the meantime, interested parties can email Neal Golden (neal.golden@usda.gov) for a copy of the manuscript.
Looking for quick answers on food safety topics?
Try Ask FSM, our new smart AI search tool.
Ask FSM →




.webp?height=200&t=1657568786&width=200)



